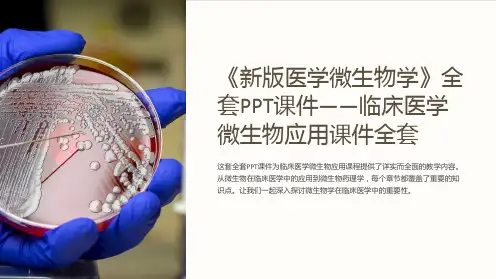

临床微生物学概论PPT课件
- 格式:ppt
- 大小:18.30 MB
- 文档页数:88

01医学微生物学概述Chapter医学微生物学的定义与任务定义任务01020304包括革兰氏阳性菌、革兰氏阴性菌等不同类型的细菌。
细菌包括DNA 病毒、RNA 病毒等不同类型的病毒。
病毒包括酵母菌、霉菌等不同类型的真菌。
真菌包括原虫、蠕虫等不同类型的寄生虫。
寄生虫古代时期文艺复兴时期19世纪20世纪至今02细菌的基本形态与结构Chapter细菌的大小与形态细菌的大小细菌的形态01020304细胞壁细胞质细胞膜核质荚膜鞭毛菌毛芽孢03细菌的生理与遗传Chapter细菌的形态与结构细菌的理化特性细菌的分类与命名030201细菌的理化性质细菌的生长繁殖与代谢细菌的营养类型细菌的生长繁殖细菌的代谢细菌的遗传与变异细菌的遗传物质细菌的变异类型细菌遗传变异的机制细菌遗传变异的意义04细菌的分类与命名Chapter细菌的分类方法数值分类法传统分类法利用细菌的多种特性,通过计算机进行数值分析,确定细菌之间的相似性和差异性,从而进行分类。
分子分类法常见病原菌的分类与命名葡萄球菌属包括金黄色葡萄球菌、表皮葡萄球菌等,引起皮肤和软组织感染、败血症等。
链球菌属包括肺炎链球菌、化脓性链球菌等,引起呼吸道感染、脑膜炎、心内膜炎等。
肠杆菌科包括大肠杆菌、沙门氏菌等,引起肠道感染、泌尿道感染等。
观察细菌的形态、大小、排列方式等特征进行初步鉴定。
形态学鉴定生理生化鉴定免疫学鉴定分子生物学鉴定利用细菌对营养物质的需求、代谢产物的产生以及某些酶的活性等特性进行鉴定。
利用特异性抗体与细菌抗原的结合反应进行鉴定,如凝集试验、沉淀试验等。
基于细菌基因序列的分析和比较,采用PCR 技术、基因芯片技术等手段进行快速、准确的鉴定。
细菌的鉴定与识别05病毒的基本形态与结构Chapter病毒的大小与形态病毒的大小病毒的形态病毒形态各异,常见的有球形、杆状、砖形、丝状、蝌蚪状等。
这些形态与病毒的基因组类型、外壳蛋白的结构以及感染宿主的方式有关。
病毒的基本结构核衣壳包膜病毒的分类与命名病毒的分类病毒的命名06病毒的复制与遗传Chapter病毒的复制周期病毒通过特异性受体吸附于宿主细胞表面,然后将核酸注入细胞内。




